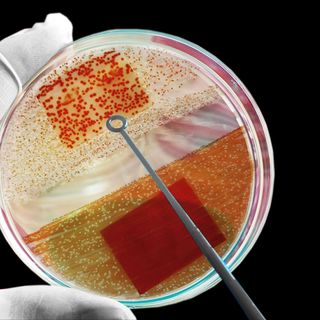

ADD and ADHD May Sound Similar, but They’re Not Interchangeable
ADD, or Inattentive ADHD, is a subtype of the medically recognized ADHD.

Attention Deficit Hyperactive Disorder (ADHD) and Attention Deficit Disorder (ADD) are often used interchangeably when referring to the disorder that causes attention problems, excess energy, and hyperactivity in inappropriate situations. However, the American Psychiatry Association only recognizes ADHD; ADD is an old term now known clinically as inattentive ADHD and classified as a subset of ADHD.
ADHD, according to the Mayo Clinic, is a chronic condition that often begins in childhood and persists into adulthood. It includes a combination of problems, such as difficulty sustaining attention, hyperactivity and impulsive behavior. There’s no way to cure ADHD, but treatment and medication can help alleviate symptoms.
There are three subtypes to ADHD: inattentive, hyperactive-impulsive and combined. Inattentive ADHD is what was previously known as ADD. When an individual has inattentive ADHD, they show symptoms of attention deficiency, but no impulsiveness or hyperactivity — which leads to the disorder often being dismissed as moodiness or apathetic behavior, due to the low energy and lack of focus associated with the disorder.
Related on The Swaddle:
ADHD in India: a Portrait of a Complex Condition
According to the Diagnostic and Statistical Manual of Mental Disorders-V, an individual can be diagnosed with inattentive ADHD (formerly ADD) if six of the following symptoms are present at a rate severe enough to cause a negative impact at school or work. These symptoms are:
- “Often fails to give close attention to details or makes careless mistakes
- Often has difficulty sustaining attention
- Often does not seem to listen when spoken to
- Often does not follow through on instructions and fails to finish projects
- Often has difficulty organizing tasks and activities
- Often avoids, dislikes, or is reluctant to engage in tasks that require sustained mental effort
- Often loses things necessary for tasks or activities
- Is often easily distracted by extraneous stimuli
- Is often forgetful in daily activities”
On the other hand, hyperactive-impulsive ADHD, which is commonly known as just ADHD, includes spur-of-the-moment decisions, fidgeting, and other constant movements. While children with inattentive ADHD (formerly ADD) can display low energy and lack of focus, children with hyperactive-impulsive ADHD are the complete opposite. According to DSM-V, six of the following symptoms can merit a diagnosis of hyperactive-impulsive ADHD:
- “Fidgets with hands or feet or squirms in seat.
- Leaves seat in classroom or in other situations in which remaining seated is expected.
- Runs about or climbs excessively in situations in which it is inappropriate (in adolescents or adults, may be limited to subjective feelings of restlessness).
- Has difficulty playing or engaging in leisure activities quietly.
- Appears ‘on the go’ or acts as if “driven by a motor.”
- Talks excessively.
- Blurts out the answers before the questions have been completed.
- Has difficulty awaiting turn.
- Interrupts or intrudes on others (e.g., butts into conversations or games)”
The third subtype — combined ADHD — occurs when six or more symptoms of inattentive ADHD, and six or more symptoms of hyperactive-impulsive ADHD occur together.
Often, male children are more often diagnosed with ADHD than female children, as boys display more hyperactive behavior stereotypical to ADHD, whilegirls display symptoms like inattentiveness and low self-esteem. This means, since the stereotype and common representation of the terms ADD and ADHD lean towards hyperactivity, girls with inattentive ADHD (formerly ADD) are less likely to be diagnosed. If there is no support and treatment given, girls can develop other mental health issues including depression, anxiety, and eating disorders. Thus, distinguishing between inattentive ADHD (formerly ADD) and hyperactive-impulsive ADHD is vital, as it helps caregivers look for and monitor specific symptoms in order to seek help.
Aditi Murti is a culture writer at The Swaddle. Previously, she worked as a freelance journalist focused on gender and cities. Find her on social media @aditimurti.
Related

All the Details on Chancroid, an STI as Unpleasant as Its Name
